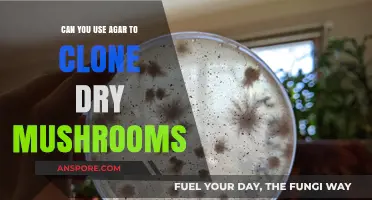
Cloning Dry Mushrooms with Agar: Techniques and Success Tips

Apple wood chips can be a viable option for mushroom substrate, depending on the mushroom species being cultivated. While traditionally, substrates like straw, sawdust, or grain are commonly used, apple wood chips offer unique advantages due to their natural nutrients and structure. They are particularly beneficial for species like oyster mushrooms, which thrive on lignin-rich materials. However, it’s essential to ensure the wood chips are properly pasteurized or sterilized to eliminate competing microorganisms and create an optimal environment for mycelium growth. Additionally, the pH and moisture content of apple wood chips should be monitored to meet the specific requirements of the mushroom species. With proper preparation, apple wood chips can serve as an effective and sustainable substrate for mushroom cultivation.
| Characteristics | Values |
|---|---|
| Suitability for Mushroom Substrate | Apple wood chips can be used as a component of mushroom substrate, but they are not typically used alone. They are often mixed with other materials like straw, sawdust, or compost. |
| Nutrient Content | Apple wood chips are low in nitrogen and high in carbon, making them a good bulking agent but insufficient as a sole nutrient source for mushrooms. |
| Moisture Retention | Wood chips have good moisture retention properties, which can help maintain the necessary humidity levels for mushroom growth. |
| pH Level | Apple wood tends to be slightly acidic, which may need adjustment depending on the mushroom species being cultivated. |
| Particle Size | Chips should be finely ground or supplemented with smaller particles to increase surface area for mycelium colonization. |
| Sterilization Requirement | Wood chips often require pasteurization or sterilization to eliminate competing microorganisms, as they can harbor bacteria and molds. |
| Common Mushroom Species | Oyster mushrooms (Pleurotus ostreatus) and other wood-degrading species are more likely to thrive on wood chip-based substrates. |
| Cost and Availability | Apple wood chips are generally affordable and readily available, especially in regions with apple orchards or woodworking industries. |
| Environmental Impact | Using apple wood chips can be sustainable, as they are often a byproduct of other industries, reducing waste. |
| Supplementation Needed | Additional nutrients like nitrogen sources (e.g., soybean meal, gypsum) are typically required to create a balanced substrate. |
| Decomposition Rate | Wood chips decompose slowly, providing a longer-lasting substrate for mushrooms compared to faster-decomposing materials like straw. |
| Ease of Use | Requires more preparation (e.g., pasteurization, supplementation) compared to pre-made substrates, but can be cost-effective for large-scale cultivation. |
Explore related products
What You'll Learn

Apple wood chip preparation for mushroom cultivation
Apple wood chips, a byproduct of pruning or milling, offer a sustainable and nutrient-rich substrate for mushroom cultivation. Their natural composition, rich in cellulose and lignin, provides an ideal environment for mycelium growth. However, raw wood chips are not immediately suitable for mushroom cultivation due to their high moisture content and potential contaminants. Proper preparation is essential to transform these chips into a viable substrate.
The first step in preparing apple wood chips involves moisture control. Freshly cut wood chips can have a moisture content exceeding 50%, which is too high for mushroom cultivation. To reduce this, spread the chips in a thin layer and allow them to air-dry for 1–2 weeks, depending on humidity levels. Aim for a moisture content of 30–40%, which can be measured using a moisture meter. Alternatively, dry the chips in an oven at 120°F (49°C) for 24–48 hours, ensuring even drying without overheating.
Once dried, the chips must be sterilized or pasteurized to eliminate competing microorganisms. For small-scale operations, pasteurization is often sufficient. Soak the chips in water heated to 160°F (71°C) for 1–2 hours, then drain and cool. For larger batches or higher sterility assurance, steam sterilization at 250°F (121°C) for 1–2 hours is recommended. This step is critical, as contaminants can outcompete mushroom mycelium and ruin the crop.
After sterilization, supplementation enhances the substrate’s nutritional profile. Apple wood chips alone may lack sufficient nitrogen for optimal mushroom growth. Mix in 10–15% by volume of a nitrogen-rich supplement, such as wheat bran, soybean meal, or cottonseed hulls. This balance ensures the mycelium receives the nutrients needed for robust colonization and fruiting.
Finally, inoculation requires precision. Use 1–2 quarts of grain spawn per 5-gallon bucket of prepared substrate, mixing thoroughly to ensure even distribution. Maintain a pH level between 5.5 and 6.5, as apple wood chips naturally lean acidic. Monitor temperature and humidity during incubation, keeping the environment at 70–75°F (21–24°C) and 60–70% humidity for optimal mycelium development. With proper preparation, apple wood chips can yield bountiful mushroom harvests while repurposing agricultural waste.
Coffee and Magic Mushrooms: A Safe or Risky Combination?
You may want to see also

Benefits of using apple wood chips for substrate
Apple wood chips, often a byproduct of orchard pruning or cider production, offer a nutrient-rich, sustainable substrate for mushroom cultivation. Their natural composition—high in cellulose, hemicellulose, and lignin—provides an ideal foundation for mycelial growth. Unlike some substrates that require extensive supplementation, apple wood chips can be used with minimal additives, making them a cost-effective and environmentally friendly option for both hobbyists and commercial growers.
One of the standout benefits of apple wood chips is their ability to retain moisture while still allowing for adequate air exchange. This balance is critical for mushroom cultivation, as mycelium thrives in a humid yet breathable environment. To optimize this, soak the wood chips in water for 24 hours before pasteurization, then drain and mix with a small amount of gypsum (1-2% by weight) to improve calcium levels and structure. This preparation ensures the substrate remains moist throughout the colonization and fruiting stages without becoming waterlogged.
From a sustainability perspective, apple wood chips align with circular economy principles. By repurposing waste material from orchards, growers reduce the demand for virgin resources and minimize agricultural waste. Additionally, apple wood’s natural resistance to decay means it can be reused for multiple grows after proper sterilization, further extending its utility. For small-scale growers, sourcing chips from local orchards or cider mills can also reduce transportation costs and carbon footprints.
Comparatively, apple wood chips offer advantages over traditional substrates like straw or sawdust. Their denser structure provides better physical support for mushrooms, reducing the risk of fruiting bodies toppling over. Furthermore, the chips’ natural sugars and minerals can enhance flavor profiles in certain mushroom species, such as shiitake or oyster mushrooms. However, it’s essential to note that apple wood’s pH tends to be slightly acidic (around 5.0–5.5), so testing and adjusting with agricultural lime may be necessary for pH-sensitive strains.
For practical implementation, start by pasteurizing the soaked and drained apple wood chips at 160°F (71°C) for 1 hour to eliminate contaminants. Allow the substrate to cool before inoculating with spawn, using a ratio of 1 part spawn to 5 parts substrate for optimal colonization. Monitor humidity levels closely during fruiting, aiming for 85–95% relative humidity, and ensure proper ventilation to prevent mold growth. With these steps, apple wood chips can serve as a reliable, nutrient-dense substrate that supports robust mushroom yields while promoting sustainable practices.
Can You Touch All Mushrooms? Safety Tips and Myths Debunked
You may want to see also

Sterilization methods for apple wood chip substrates
Apple wood chips, with their dense structure and potential nutrient content, can serve as a viable substrate for mushroom cultivation. However, their natural microbial load necessitates thorough sterilization to prevent contamination. Several methods exist, each with unique advantages and considerations.
Pressure Cooking: The Gold Standard
The most reliable method for sterilizing apple wood chips is pressure cooking. This process utilizes steam under pressure to achieve temperatures exceeding 121°C (250°F), effectively eliminating bacteria, fungi, and spores. To sterilize, fill your pressure cooker with a mixture of apple wood chips and water, ensuring the chips are submerged. Process at 15 psi for 90 minutes, allowing for adequate heat penetration. This method, while time-consuming, guarantees a sterile environment for mushroom mycelium to thrive.
Chemical Sterilization: A Faster Alternative
For those seeking a quicker approach, chemical sterilization using hydrogen peroxide (H₂O₂) can be considered. A 3% solution of H₂O₂ can be applied directly to the wood chips, followed by thorough mixing and a 24-hour soaking period. This method is less reliable than pressure cooking, as it may not penetrate deeply enough to eliminate all contaminants. Additionally, residual H₂O₂ can potentially inhibit mycelium growth, requiring careful rinsing before inoculation.
Steaming: A Middle Ground
Steaming offers a compromise between the thoroughness of pressure cooking and the speed of chemical sterilization. By exposing the wood chips to steam for an extended period (typically 1-2 hours), many surface contaminants can be eliminated. However, steaming may not reach the core of denser wood chips, leaving potential pockets of contamination. This method is best suited for smaller batches and requires careful monitoring to ensure adequate steam penetration.
Choosing the Right Method: Considerations
The optimal sterilization method depends on factors like batch size, desired sterility level, and available equipment. Pressure cooking remains the most foolproof method, but its time commitment may be impractical for large-scale operations. Chemical sterilization offers speed but carries risks of residual chemicals and incomplete penetration. Steaming provides a balance but requires careful execution. Ultimately, the choice hinges on the specific needs and resources of the cultivator.
Can Rabbits Safely Eat Raw Mushrooms? A Complete Guide
You may want to see also
Explore related products

Compatibility with different mushroom species
Apple wood chips, with their naturally sweet and slightly fruity aroma, offer a unique substrate option for mushroom cultivation. However, not all mushroom species thrive on this medium. Compatibility depends on the specific nutritional and environmental needs of each fungus. For instance, oyster mushrooms (*Pleurotus ostreatus*) are highly adaptable and often flourish on apple wood chips due to their ability to break down lignin and cellulose efficiently. The chips provide a balanced structure that supports mycelial growth while retaining adequate moisture, crucial for fruiting.
In contrast, shiitake mushrooms (*Lentinula edodes*) require a more precise substrate composition. While apple wood chips can be used, they should be supplemented with hardwood sawdust or bran to meet the species’ higher nitrogen demands. A ratio of 70% apple wood chips to 30% sawdust or bran is recommended to ensure optimal growth. This blend mimics the nutrient profile of their natural habitat, promoting robust fruiting bodies.
For more delicate species like lion’s mane (*Hericium erinaceus*), apple wood chips alone may not suffice. This mushroom prefers a softer, more nutrient-dense substrate, such as supplemented sawdust or straw. However, incorporating a small percentage (20–30%) of apple wood chips can enhance flavor and texture without compromising growth. Experimentation is key, as lion’s mane responds well to subtle variations in substrate composition.
When cultivating reishi (*Ganoderma lucidum*), a medicinal mushroom with unique requirements, apple wood chips can be a viable option but must be aged or pasteurized to reduce potential contaminants. Reishi thrives on hardwoods, and apple wood’s density aligns with its preferences. However, the chips should be finely ground to increase surface area, facilitating better mycelial colonization.
Ultimately, the compatibility of apple wood chips with different mushroom species hinges on understanding their specific needs. While versatile, this substrate is not a one-size-fits-all solution. Tailoring its use through supplementation, processing, or blending ensures successful cultivation across a range of fungi, from the resilient oyster to the demanding reishi.
Risky Business: Eating Moldy Magic Mushrooms – Safe or Dangerous?
You may want to see also

Cost-effectiveness of apple wood chips in mushroom farming
Apple wood chips, a byproduct of the timber and orchard industries, offer a potentially cost-effective substrate for mushroom farming. Their availability in regions with apple orchards can significantly reduce material costs compared to traditional substrates like straw or sawdust. For instance, in the Pacific Northwest of the United States, where apple production is high, farmers can source wood chips locally at a fraction of the cost of imported materials. This localized sourcing not only cuts transportation expenses but also aligns with sustainable farming practices by utilizing waste products.
However, cost-effectiveness isn’t solely determined by the price of the substrate. The nutrient content and preparation requirements of apple wood chips must also be considered. Apple wood is denser and harder than softer woods like poplar or alder, which means it requires more energy for chipping and sterilization. Farmers should factor in the cost of machinery wear and tear, as well as the energy consumption for autoclaving or pasteurizing the chips. Despite this, the chips’ durability can be an advantage, as they break down more slowly, potentially extending the substrate’s usability over multiple mushroom cycles.
To maximize cost-effectiveness, farmers should experiment with blending apple wood chips with other substrates. A 50/50 mix of apple wood chips and straw, for example, can balance the chips’ density with the straw’s airiness, creating an optimal growing environment for mushrooms like shiitake or oyster varieties. This approach reduces the overall cost per batch while maintaining the structural integrity needed for mycelium colonization. Additionally, supplementing the substrate with 5-10% wheat bran or soybean meal can enhance nutrient availability without significantly increasing expenses.
A critical factor in assessing cost-effectiveness is yield per unit of substrate. Apple wood chips, when properly prepared, can support robust mushroom growth, but their density may limit oxygen availability, affecting fruiting efficiency. Farmers should monitor CO₂ levels in the growing environment and ensure adequate ventilation to counteract this. For small-scale operations, the higher initial investment in apple wood chips may be offset by consistent yields and reduced need for frequent substrate replacement. However, large-scale farms must carefully calculate the return on investment, considering both yield and operational costs.
In conclusion, apple wood chips present a viable, cost-effective substrate option for mushroom farming, particularly in regions with abundant apple wood waste. While their density and preparation requirements may increase upfront costs, strategic blending, nutrient supplementation, and efficient growing practices can optimize their use. Farmers should conduct small-scale trials to determine the ideal chip-to-supplement ratio and assess long-term cost savings before scaling up production. By leveraging local resources and innovative techniques, apple wood chips can become a sustainable and economical choice in the mushroom farming industry.
Can You Eat Mushrooms on an Elimination Diet? A Guide
You may want to see also
Frequently asked questions
Yes, apple wood chips can be used as a substrate for growing mushrooms, especially for species like oyster mushrooms, which thrive on hardwoods.
Yes, apple wood chips should be pasteurized or sterilized to eliminate competing microorganisms and ensure a clean environment for mushroom growth.
Apple wood chips are best suited for saprotrophic mushrooms like oyster mushrooms, shiitake, and lion's mane, which naturally decompose hardwoods.
Yes, apple wood chips can be mixed with supplements like straw, sawdust, or bran to improve nutrient content and water retention for optimal mushroom growth.